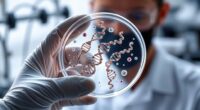
genetic causes of hearing loss

If you’re looking for the best car seat covers to protect and refresh your vehicle interior, I recommend options that combine durability, style, and safety. High-quality materials like faux leather, reinforced textiles, and waterproof fabrics provide full coverage and resist stains, spills, pet claws, and UV rays. Features like adjustable straps, airbag-safe stitching, and easy maintenance make installation and upkeep simple. Stay with me, and I’ll share top picks that meet these needs perfectly.
Key Takeaways
- High-quality, waterproof, and stain-resistant materials offer durable protection against spills, pet claws, UV rays, and daily wear.
- Full-coverage designs with adjustable straps and safety openings ensure a secure fit and compatibility with airbags and seat belts.
- Stylish options like quilted patterns, vibrant accents, and textured finishes refresh and enhance your vehicle’s interior aesthetic.
- Easy-to-install, machine-washable covers provide hassle-free maintenance and long-term protection for all vehicle types.
- Safety features such as airbag-safe stitching and non-slip backing ensure protection, security, and unobstructed seat functions.
Skechers Men’s Memory Foam Car Seat Covers
If you’re looking for a seat cover that combines comfort and breathability, Skechers Men’s Memory Foam Car Seat Covers are an excellent choice. I love how their Skechers Memory Foam(TM), Leather, and Air-Cool Mesh materials contour to my body and relieve pressure during long drives. The cooling mesh top layer feels smooth and breathable, keeping me comfortable and cool. Designed to fit most vehicles, they’re easy to slip in and out, offering full protection and style. Plus, they’re compatible with airbags and seat belts, so safety isn’t compromised. Overall, these covers deliver a perfect balance of comfort, protection, and airflow, making every drive more enjoyable.
Best For: drivers seeking maximum comfort, breathability, and protection for their vehicle seats during long drives.
Pros:
- Contours to the body for personalized comfort and pressure relief with Skechers Memory Foam(TM)
- Breathable, cooling Air-Cool Mesh top layer enhances airflow and keeps users cool
- Compatible with airbags and seat belts, offering full protection without sacrificing safety
Cons:
- May not fit all vehicle seat sizes perfectly due to its universal design
- Installation might require some effort to slip the covers securely into place
- The slip-in style may shift over time with frequent use, requiring readjustment
CAR PASS Faux Leather Car Seat Covers for Front Seats
The CAR PASS Faux Leather Car Seat Covers are an excellent choice for drivers seeking a stylish, durable upgrade to their front seats. Made from modern faux leather with 3D foam back support, they boost your vehicle’s interior aesthetics with a touch of luxury. The universal semi-customized fit, secured by hook-and-loop attachments and seat straps, guarantees a snug fit in most cars, trucks, or SUVs. Safety is a priority, as these covers are airbag-compatible with special stitching that allows safe deployment. Plus, the foam padding offers great support, reducing fatigue on long drives while full coverage protects your seats from spills, dirt, and kicks.
Best For: drivers seeking a stylish, protective, and safe upgrade for their front seats that fits most vehicle types.
Pros:
- Stylish modern faux leather with 3D foam back support enhances interior aesthetics and comfort.
- Universal semi-customized fit with hook-and-loop attachments ensures a snug, secure fit across various vehicle models.
- Airbag-compatible design with special stitching guarantees safety during deployment while providing full seat coverage.
Cons:
- May require some adjustment during installation for a perfect fit in certain vehicle seats.
- Faux leather material might not be as breathable as fabric, potentially leading to less ventilation.
- Universal fit may not accommodate very irregular or heavily contoured seat shapes perfectly.
FH Group Car Seat Covers Full Set
Looking for a versatile car seat cover set that offers a perfect fit and easy maintenance? The FH Group Car Seat Covers Full Set is designed with a semi-customized fit using hook-and-loop attachments, straps, and adjustable features, making installation straightforward. It’s compatible with split bench rear seats and includes covers for 2 front seats, a rear bench, and 5 headrest covers, including zippers for added convenience. Made from heavy-duty 3-layer cloth with breathable mesh, it’s built to withstand daily wear and tear. Plus, it’s machine washable, ensuring easy cleaning. With 11 color options and a stylish look, it’s a practical upgrade for any vehicle interior.
Best For: drivers seeking a durable, easy-to-maintain, and customizable seat cover set that fits most vehicles and enhances interior style.
Pros:
- Semi-customized universal fit with adjustable features for a snug and secure installation
- Made of heavy-duty, breathable 3-layer cloth for long-lasting durability and protection
- Machine washable for effortless cleaning and maintenance
Cons:
- Designed primarily for low-back front seats, may not fit high-back or specialized seats perfectly
- May require some effort for installation, especially with zippers and adjustable straps
- Limited to 11 color options, which might not match all vehicle interiors perfectly
BDK PolyPro Car Seat Covers Full Set in Charcoal
The BDK PolyPro Car Seat Covers Full Set in Charcoal are an excellent choice for drivers seeking a stylish and durable upgrade that fits most vehicles. These covers offer a universal fit for cars, trucks, vans, and SUVs with adjustable or removable headrests, making installation straightforward with step-by-step instructions and video support. They protect against dirt, spills, and daily wear, helping preserve your vehicle’s interior and resale value. Made from breathable, all-season materials, they guarantee comfort in any climate. The modern two-tone design with detailed stitching adds a sleek, contemporary look, instantly rejuvenating and enhancing your vehicle’s interior.
Best For: drivers seeking a stylish, durable, and easy-to-install seat cover set that offers all-season comfort and universal compatibility for most vehicles.
Pros:
- Universal fit compatible with most cars, trucks, vans, and SUVs with adjustable/removable headrests
- Made from breathable, all-season materials for enhanced comfort in any climate
- Modern two-tone design with detailed stitching to upgrade vehicle interior aesthetically
Cons:
- Not suitable for seats with molded, non-adjustable headrests or built-in armrests on front seats
- May require some adjustment to achieve a perfect fit depending on vehicle interior design
- Does not include built-in armrest covers or integrated seatbelt covers
Car Seat Protector for SUVs, Sedans, Trucks
If you want reliable protection for your vehicle’s seats, this car seat protector is an excellent choice, especially for families with children or pets. It’s made from durable 600D Oxford fabric that’s weatherproof, stain-resistant, and waterproof, making cleanup a breeze. The protector covers the seat bottom, backrest, and includes mesh pockets for storage. It’s adjustable, slip-resistant, and fits most SUVs, sedans, and trucks. Plus, it’s compatible with safety seats and doesn’t transfer dye or melt at high temperatures. Easy to install, it keeps your seats safe from spills, scratches, and pet messes, all while providing a secure, comfortable fit.
Best For: Families with children and pet owners seeking durable, waterproof protection for their vehicle seats.
Pros:
- Made from high-quality, weatherproof 600D Oxford fabric that is stain- and waterproof, ensuring easy cleanup and long-lasting protection.
- Fully covers seat bottom, backrest, and includes mesh pockets for convenient storage, fitting most vehicles including SUVs, sedans, and trucks.
- Adjustable straps and anti-slip dots provide a secure, slip-resistant fit, enhancing safety and comfort during travel.
Cons:
- May require some adjustment for a perfect fit in extremely small or irregularly shaped seats.
- Slightly heavier than minimal seat covers, which might be noticeable during long trips or frequent installations.
- Mesh pockets, while convenient, could be less secure for very small or loose items during vigorous driving.
CAR PASS Leather Seat Covers Full Set for Vehicles
For anyone seeking stylish and durable protection for their vehicle’s seats, the CAR PASS Leather Seat Covers Full Set is an excellent choice. Made from high-quality faux leather with 3D foam back support, they offer a modern, luxurious look that elevates your interior. The all-black, sport-inspired design adds a sleek touch, while full coverage shields front and back seats from dirt, damage, and kicks. Features like airbag-safe stitching, waterproof construction, and easy installation make these covers highly functional. With a semi-custom fit suitable for most vehicles, they deliver comfort, protection, and style in one complete package.
Best For: Drivers seeking stylish, durable, and full-coverage seat protection with enhanced comfort and safety features for most vehicle types.
Pros:
- Made from high-quality faux leather with plush 3D foam back support for a luxurious look and added comfort.
- Full coverage design shields seats from dirt, damage, and kicks, suitable for all seasons and vehicle types.
- Features airbag-safe stitching, waterproof construction, and easy installation for safe, reliable, and hassle-free use.
Cons:
- Universal fit may require adjustments for a perfect semi-custom look in some vehicle models.
- May not fit exceptionally tight in all vehicle interiors due to semi-custom design.
- Slightly higher price point compared to basic seat covers, reflecting premium materials and features.
Coverado Car Seat Covers Full Set
Looking to upgrade your car’s interior with a touch of luxury and protection? The Coverado Car Seat Covers Full Set offers just that, combining modern design with high-quality NAPPA Leather for a premium feel. Its luxury 3D modeling and lumbar support add style and comfort, while the universal fit suits most cars, SUVs, and trucks—just measure your seats first. These covers shield your seats from spills, stains, pet hair, and UV rays, ensuring long-lasting durability. Easy to install with simple hooks and straps, they preserve seat features like airbags and adjustments. Once installed, they provide reliable, long-term protection and a fresh, upgraded look.
Best For: car owners seeking a luxurious, durable, and easy-to-maintain seat protection upgrade compatible with most vehicle types.
Pros:
- Stylish luxury design with 3D modeling and lumbar support enhances interior aesthetics and comfort
- Made from high-quality NAPPA Leather for durability, waterproofing, and resistance to fading and UV rays
- Easy installation with hooks and straps ensures a secure fit and long-term protection without complicated setup
Cons:
- Universal fit may require measuring seats beforehand to ensure proper alignment
- May need periodic maintenance to keep the leather looking new and clean
- Limited color options might not match all vehicle interior styles
Leather Car Seat Cover Full Set, Waterproof Seat Covers, Universal Fit Black
The Leather Car Seat Cover Full Set is an excellent choice for drivers seeking a sleek, durable upgrade that fits most vehicles. Made from premium Nappa leather, it offers a stylish, classic look with smooth lines that enhance your interior. The universal fit and easy installation mean you can quickly refresh your car without hassle. It maintains seat functions like airbags, seatbelts, and adjustments, ensuring safety. The waterproof design protects against spills, while the faux leather material is easy to clean and built for long-lasting durability. Fixing straps keep the covers securely in place, making this set both practical and visually appealing.
Best For: drivers seeking a stylish, durable, and easy-to-install seat cover set that fits most vehicles and offers protection against spills.
Pros:
- Made from premium Nappa leather with a classic, stylish design
- Waterproof and easy to clean, ensuring long-lasting durability
- Maintains all seat functions including airbags and adjustments for safety
Cons:
- May require some adjustments to fit very specific vehicle models perfectly
- Slightly heavier than fabric covers, which could affect ease of handling during installation
- Limited color options, primarily available in black
Car Seat Cover for Luxury & Comfort
If you want your vehicle’s interior to exude luxury and provide maximum comfort, these car seat covers are an excellent choice. They offer complete wrap-around protection with a sleek, seamless design that blends with your seats. The elegant triangle quilted pattern adds a stylish touch while the slightly raised triangles boost comfort on long drives. Made from upgraded, waterproof PU leather, they’re durable and easy to clean. The full wrap includes a handy storage pocket, and the anti-slip gel bottom keeps everything stable. Plus, they fit 95% of vehicles and are simple to install, making your upgrade quick and hassle-free.
Best For: Drivers seeking a luxurious, durable, and easy-to-maintain car seat cover that offers full protection and comfort for long drives.
Pros:
- Comprehensive wrap-around protection with a seamless, sleek design that enhances vehicle interior aesthetics.
- Made from upgraded waterproof PU leather, ensuring durability, easy cleaning, and long-lasting use.
- Features a stylish triangle quilted pattern with raised triangles for added comfort and a modern look.
Cons:
- May not fit certain non-standard or very small vehicle seats despite universal sizing claims.
- Installation, while simple, might require adjustment to ensure perfect fit and anti-slip stability.
- Color options are limited, with gray being the primary available shade.
Elantrip 2-Pack Leather Waterproof Car Seat Covers
For anyone seeking a durable and stylish upgrade to protect their vehicle seats, the Elantrip 2-Pack Leather Waterproof Car Seat Covers are an excellent choice. Made from premium leather and tear-resistant, waterproof fabric, they combine luxury with rugged protection, guarding against spills, pet claws, UV damage, and daily wear. Their diamond design with a removable pillow adds a touch of elegance, while hidden straps ensure safety and unobstructed airbag deployment. Easy to install in under 10 minutes and compatible with most models from 2002 to 2024, these covers are low-maintenance and come with a 180-day customer support guarantee.
Best For: individuals seeking a durable, stylish, and easy-to-maintain seat cover solution that offers maximum protection for various vehicle types from 2002 to 2024.
Pros:
- Crafted from premium leather and tear-resistant, waterproof fabric for long-lasting durability
- Easy to install within 10 minutes without tools, with a universal fit for most vehicle models
- Designed with hidden straps for safety, unobstructed airbag deployment, and a sophisticated diamond pattern with removable pillow
Cons:
- May not fit perfectly on ultra-specific or non-standard seat shapes despite universal design
- Limited color options (if applicable) could restrict style customization
- Requires regular wiping to maintain appearance, especially in dusty or muddy conditions
CAR PASS Line Rider Sporty Front Seat Covers
Looking to add a sporty, eye-catching touch to your vehicle’s interior? The CAR PASS Line Rider Sporty Front Seat Covers in vibrant rainbow colors are perfect for that. Designed with a sleek, sporty look, they instantly upgrade your car’s appearance while fitting most sedans, vans, SUVs, and trucks. Made from breathable, wrinkle-resistant material, they feel comfortable during long drives. Installation is straightforward with four pieces—covering seats and headrests—and they include reserved openings for airbags, seat belts, and headrests for safety. Plus, their stylish appeal often earns compliments, making them a practical and attractive upgrade for any vehicle interior.
Best For: car owners seeking a stylish, vibrant, and easy-to-install upgrade to enhance their vehicle’s interior appearance and safety.
Pros:
- Bright, sporty rainbow design adds a unique and attractive look to your vehicle.
- Made with breathable, wrinkle-resistant material for comfort during drives.
- Easy to install with reserved openings for airbags, seat belts, and headrests, ensuring safety and compatibility.
Cons:
- Universal fit may not perfectly suit all vehicle models or seat shapes.
- Vibrant colors may fade over time with frequent washing or exposure to sunlight.
- Limited color options beyond the rainbow design for those seeking different styles.
CAR PASS Leather Car Seat Cover Set for SUVs, Vans, Trucks
The CAR PASS Leather Car Seat Cover Set is an excellent choice for SUV, van, and truck owners who want durable, eco-friendly protection that’s easy to install. Crafted from high-quality PU leather with soft sponge padding, it resists wrinkles, dust, and scratches. The set includes everything needed—front and backseat covers, headrests, and clips—designed to fit most vehicles with reserved holes for seat belts and airbags. Its zipper design allows split configurations like 40/60 or 50/50, and features like foldable cup holders add convenience. Plus, it’s breathable, washable, and environmentally friendly, making it perfect for maintaining a fresh, protected interior.
Best For: SUV, van, and truck owners seeking durable, eco-friendly, and easy-to-install seat covers with customizable configurations.
Pros:
- Made from high-quality, wrinkle-resistant PU leather with soft sponge padding for comfort and durability
- Compatible with airbags and seat belts, featuring reserved holes and zipper design for split configurations and foldable cup holders
- Breathable, washable, and environmentally friendly, offering dust and scratch protection with simple installation
Cons:
- Universal fit may not perfectly match all vehicle seat shapes and sizes
- Some users may find the zipper and opening holes require precise installation for optimal fit
- Limited color options and style variations might not suit all interior aesthetics
Back Seat Cover, Waterproof Car Seat Protector
If you want to keep your backseat spotless and protected from pet scratches, spills, and kid messes, a waterproof car seat protector is an essential accessory. I recommend the 900D Oxford waterproof cover, which fits cars, SUVs, trucks, and split bench seats. It offers full coverage, shielding the entire rear bench from fur, drool, urine, and sticky spills. Made with durable, multi-layer construction, it resists mud and pet paws without any chemical smell. The plush padding adds comfort, while seat anchors and anti-slip backing keep it secure. Easy to install and clean, it’s perfect for busy families and pet owners who want hassle-free protection.
Best For: families, pet owners, and rideshare drivers seeking reliable, full-coverage protection for their backseats against messes, scratches, and wear.
Pros:
- Waterproof multi-layer construction with durable 900D Oxford material
- Full coverage design protects entire rear bench from fur, spills, and pet paws
- Easy to install, remove, and clean with machine wash and quick adjustments
Cons:
- May not fit extremely small or oversized seats perfectly without proper size selection
- Some users might find the plush padding adds bulk to the seat area
- Limited color options could restrict matching with certain vehicle interiors
CAR PASS Car Seat Covers Full Sets
Car PASS Car Seat Covers Full Sets are an excellent choice for drivers seeking a versatile and stylish protection solution that fits most vehicles. Made from 3D tyre-embossed premium cloth, these covers are breathable for summer and warm for winter, ensuring year-round comfort. They feature a sleek appearance, enhancing your interior and earning compliments. Designed with universal fit, they work with various split rear seats and include cutouts for headrests and seat belts, making installation quick and easy. Plus, they’re airbag compatible, durable, and easy to clean, giving you peace of mind and a fresh, protected look for your vehicle.
Best For: drivers seeking a stylish, durable, and versatile seat cover set that fits most vehicles and enhances interior appearance.
Pros:
- Made from breathable 3D tyre-embossed premium cloth for year-round comfort.
- Universal fit with easy installation, compatible with various split rear seat configurations.
- Safe for airbags with exclusive patent design, durable, and simple to clean.
Cons:
- Customer ratings are around 3.9 out of 5 stars, indicating some users may experience fit or quality issues.
- May not fit extremely custom or non-standard vehicle interiors perfectly.
- Limited color options (mainly black and charcoal) may not match all interior styles.
FLORICH Leather Seat Covers for Cars and Trucks
FLORICH Leather Seat Covers are an excellent choice for drivers seeking full-coverage protection that doesn’t compromise safety or comfort. Designed to fit over 95% of cars and trucks, they are compatible with airbags, seatbelts, and massage functions. Made from breathable Nappa leather and durable leatherette, they feel smooth and gentle while resisting stains, water, and fading. Filled with high-resilient foam, they boost comfort during long drives. The full envelope design provides 360° protection, with easy access to airbags and seat belts. Plus, front seat back pockets add convenient storage, all without sacrificing your vehicle’s original safety features.
Best For: drivers seeking full-coverage, durable, and safe seat protection that enhances comfort without hindering vehicle features.
Pros:
- Compatible with most vehicles, including airbags, seatbelts, and massage functions.
- Made from breathable, high-quality Nappa leather and leatherette for comfort and durability.
- Provides 360° protection with easy access to safety features and includes convenient storage pockets.
Cons:
- May require verifying model compatibility before purchase.
- Installation could be time-consuming for some users.
- May be priced higher than basic seat covers due to premium materials and full coverage design.
Factors to Consider When Choosing Car Seat Covers

When choosing car seat covers, I look at durability to make certain they last, and I check for universal fit to match my vehicle. Safety features matter too, so I pick covers that don’t compromise airbags or seatbelt function. Finally, I consider how easy they are to install and how well their style complements my car’s interior.
Material Durability
Choosing the right car seat cover means paying close attention to the materials’ durability. I look for high-quality fabrics like heavy-duty polyester, leather, or reinforced textiles that can withstand daily wear and tear. Thick padding, around 3mm or more, adds durability and comfort during long drives. Water- and stain-resistant features, found in faux leather or Oxford fabric, help protect against spills and damage, extending the cover’s lifespan. Reinforced stitching, especially at seams and around airbags, ensures the cover stays intact under stress and deployment. Additionally, fade-resistant and UV-protected materials prevent sun damage, keeping the covers looking fresh over time. Prioritizing durable materials means my seats stay protected and looking new longer.
Universal Compatibility
Selecting a car seat cover that fits well involves paying attention to its universal compatibility. I look for covers designed to suit most vehicle types, including sedans, SUVs, trucks, and vans. Adjustable straps, hook-and-loop fasteners, and elastic features are essential, as they help secure the cover snugly on different seat shapes and sizes. I also check for reserved openings for seat belts, airbags, and seat adjustments to ensure safety isn’t compromised. Compatibility with split or bench seats, whether in the front or rear, is important for a proper fit. To confirm reliability, I review product descriptions and customer feedback, ensuring the universal fit claims hold true for various seat dimensions and features. A well-fitting cover not only looks good but also offers maximum protection.
Safety Features
Ensuring your car seat cover prioritizes safety is essential, especially with features that support airbag deployment and crash protection. I look for covers with specific stitching or designs that allow airbags to deploy properly, reducing risk during emergencies. It’s important to verify that the covers have passed safety testing and meet automotive safety standards. I also check that seat belt access remains unobstructed so that safety functions aren’t compromised. Non-slip backing or anti-slip dots are vital to prevent shifting, which could interfere with airbags or seat belts. Additionally, I prefer covers made from fire-resistant or flame-retardant materials to enhance safety in case of fire. These features give me peace of mind, knowing that my seat covers protect without sacrificing safety during accidents.
Ease of Installation
Installing a car seat cover should be straightforward, so I look for models with adjustable straps, buckles, or hook-and-loop fasteners that make the process quick and secure. Clear, step-by-step instructions or installation videos also help me avoid frustration and guarantee proper fitting. I prefer covers that are compatible with my vehicle’s seat features, like airbags and seatbelt access, so I don’t struggle with adjustments later. Lightweight and flexible materials make maneuvering easier, especially when fitting over existing seats. Features like quick-release clips or elastic edges are a plus because they provide a snug fit without tools or extensive effort. Overall, choosing a cover that’s simple to install saves time and makes the upgrade hassle-free, so I can enjoy my refreshed interior sooner.
Style and Design
When choosing a car seat cover, style and design play a big role in how well it complements your vehicle’s interior. I consider the fit, whether full coverage, semi-custom, or universal, to match my aesthetic preferences. The material choice impacts the look, comfort, and how well it blends with my interior decor; I often opt for leather or faux leather for a sleek look or cloth for a casual vibe. Patterns like quilted or diamond-stitch add a touch of elegance, while textures and colors—from neutral blacks and grays to bold hues—allow me to personalize my car’s appearance. Decorative details like piping or embroidery also help reflect my style, making the interior feel refreshed and uniquely mine.
Maintenance Requirements
Choosing the right seat covers means thinking about how easy they are to clean and maintain over time. I look for covers that are machine washable or simple to hand wash, so I won’t struggle with complicated cleaning routines. Materials like leather or polyester should be stain and spill resistant, helping them stay fresh longer. I also prefer covers with removable parts or covers that can be easily detached for quick cleaning or replacement. The cleaning process itself should be straightforward, not requiring special equipment or harsh chemicals. Protective features like waterproof or stain-resistant coatings are a bonus, as they minimize the frequency of cleaning and effort needed. Ultimately, I want seat covers that combine durability with hassle-free maintenance to keep my vehicle looking sharp.
Frequently Asked Questions
Are Car Seat Covers Safe for Airbag Deployment?
Yes, car seat covers are generally safe for airbag deployment if they’re designed specifically for that purpose. I always look for covers labeled as “airbag compatible,” ensuring they won’t obstruct the airbags when they deploy. It’s important to choose covers that fit well and are made from breathable, flexible materials. That way, you stay protected and your airbags work effectively, keeping you safe in any situation.
How Do I Clean and Maintain Different Seat Cover Materials?
To clean different seat cover materials, I follow specific steps. For fabric covers, I vacuum, spot clean with mild soap, and air dry. Leather covers get wiped with a damp cloth and conditioned regularly. For synthetic materials, I use a gentle cleaner and avoid harsh chemicals. I check manufacturer instructions first, and I maintain my covers regularly to keep them looking fresh and protected, ensuring they last longer.
Do Seat Covers Affect Seatbelt Functionality?
You might think seat covers could sabotage your seatbelt, but honestly, they usually don’t. I’ve found that quality covers are designed to fit snugly without interfering with the seatbelt’s latch or retracting mechanism. Just make sure to choose covers that are compatible with your seat’s design. So, relax—your safety gear stays safe, even under a stylish new cover. Trust me, protection and style can go hand in hand.
Can Seat Covers Be Installed on Heated or Cooled Seats?
Yes, seat covers can be installed on heated or cooled seats, but you need to choose ones compatible with such features. I recommend selecting covers made from breathable, heat-resistant materials that won’t interfere with seat heating or cooling functions. It’s essential to make sure the cover fits snugly without blocking vents or sensors, so you get protection without sacrificing comfort or the seat’s original performance.
Are Custom-Fit Seat Covers More Durable Than Universal Ones?
Yes, I believe custom-fit seat covers tend to be more durable than universal ones. They’re designed specifically for your vehicle’s make and model, ensuring a snug, secure fit. This precision prevents slipping, sagging, and unnecessary wear. Plus, custom covers often use higher-quality materials, which means they last longer and resist tears better. So, for a perfect, long-lasting fit that protects your seats, custom-fit covers are the way to go.
Conclusion
Choosing the right car seat cover is like giving your vehicle a fresh coat of armor—protecting and invigorating it for miles to come. With so many great options out there, you’ll find one that fits your style and needs perfectly. Remember, a good seat cover isn’t just an accessory; it’s a shield that keeps your car looking new and feeling comfortable. So go ahead, give your ride the upgrade it deserves!